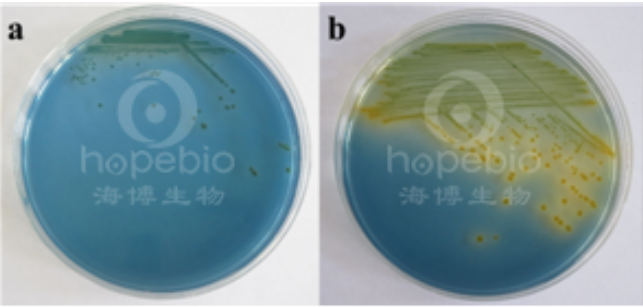
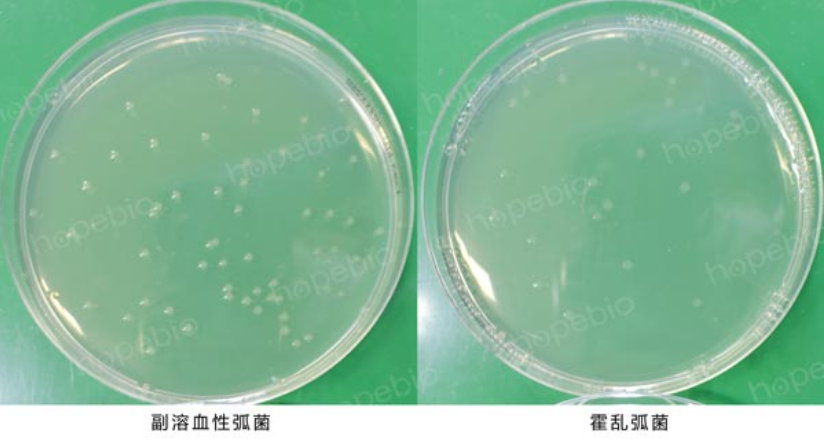
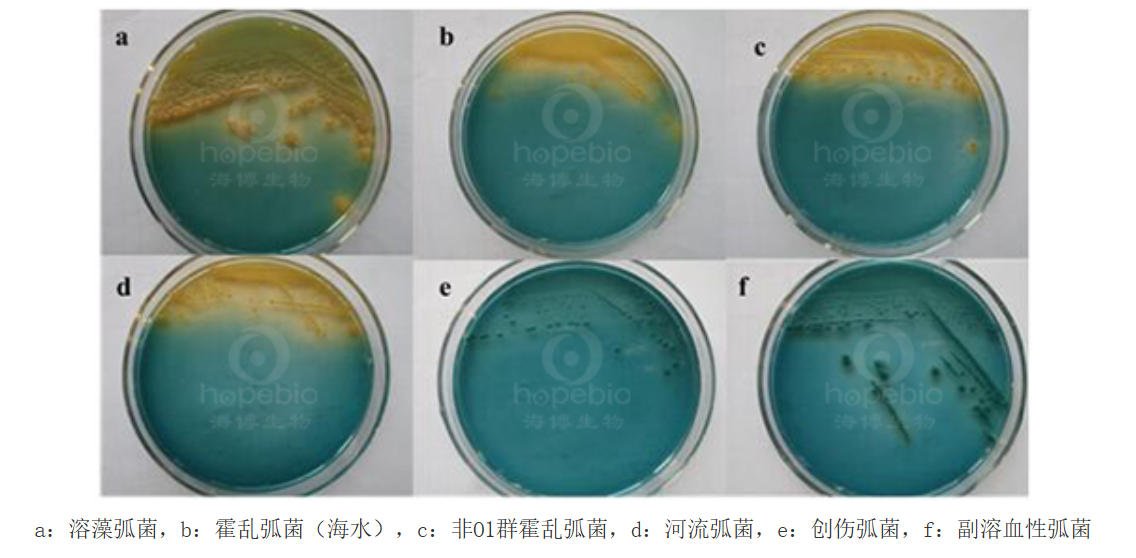

海博微信公众号
海博微信公众号
 海博天猫旗舰店
海博天猫旗舰店


 海博微信公众号
海博微信公众号
 海博天猫旗舰店
海博天猫旗舰店




一、弧菌简介
弧菌属(Vibrio)为革兰氏阴性无芽孢杆菌,菌体呈直杆状或弧状,具有极生鞭毛运动结构,氧化酶阳性且代谢方式多为发酵型。该属成员广泛分布于淡水、海水及鱼类或人类肠道中,多数菌种对营养要求不高,可在含2%-3%氯化钠的培养基中生长。部分菌种如副溶血弧菌、霍乱弧菌、创伤弧菌具有致病性,可通过皮肤创伤接触或食用污染海鲜感染免疫力低下人群。
副溶血性弧菌(Vibrio parahaemolyticus),为革兰氏阴性杆菌,呈弧状、杆状、丝状等多种形状,无芽孢。进食含有该菌的食物可致食物中毒,也称嗜盐菌食物中毒。临床上以急性起病、腹痛、呕吐、腹泻及水样便为主要症状。副溶血性弧菌是一种海洋细菌,主要来源于鱼、虾、蟹、贝类和海藻等海产品。此菌对酸敏感,在普通食醋中5分钟即可杀死;对热的抵抗力较弱。
霍乱弧菌(Vibrio cholerae)是革兰氏阴性菌,菌体短小呈逗点状,有单鞭毛、菌毛,部分有荚膜。共分为139个血清群,其中O1群和O139群可引起霍乱。霍乱弧菌是人类霍乱的病原体,霍乱是一种古老且流行广泛的烈性传染病之一。曾在世界上引起多次大流行,主要表现为剧烈的呕吐,腹泻,失水,死亡率甚高。属于国际检疫传染病。
创伤弧菌(Vibrio vulnificus)归属弧菌科弧菌属,为革兰氏阴性杆菌,也称海洋弧菌,与霍乱弧菌、副溶血弧菌并列为人类感染疾病之三大弧菌之一。最早由美国疾病控制与预防中心(CDC)于1964年分离出来,1979年Farmer将其命名为创伤弧菌。其形态学特征有较高的辨识度,镜下呈逗点状、直棒状或球粒状,有鞭毛。需氧和厌氧均能生长,具有嗜盐性,易存活于中等盐度的水体中,几乎不存在于高盐度水体中。创伤弧菌主要分布于温带、热带和亚热带地区的海洋和河口中,常寄生在贝壳类的海洋生物中。
溶藻性弧菌(Vibrio alginolyticus)是弧菌科弧菌属的革兰氏阴性嗜盐性细菌,曾于《Bergey氏细菌学鉴定手册》第八版被归类为副溶血性弧菌的生物型,后独立成种。该菌广泛分布于海水环境,1973年被确认对人类具有致病性,可通过污染食物引发腹泻或创伤感染。该菌与河流弧菌、拟态弧菌等同属嗜盐性弧菌,多活跃于夏秋季节的沿海水域。感染途径包括摄入受污染的海产品或通过皮肤伤口接触海水,临床表现以急性胃肠炎为主,伴有腹痛、呕吐及水样便,重症者可能出现败血症或休克。
二、弧菌常用的分离培养基
1、TCBS琼脂
(1)检验原理
蛋白胨、酵母浸粉在培养基中作为基础营养物质提供菌体生长所需的氮源、碳源及维生素等各种生长因子;较高浓度的氯化钠满足弧菌嗜盐生长的需要;蔗糖作为可发酵碳源;枸橼酸钠、高pH碱性环境及硫代硫酸钠的存在抑制肠道菌的生长,牛胆粉、牛胆酸钠主要抑制革兰氏阳性菌的生长,此外,硫代硫酸钠还提供硫源,在柠檬酸铁存在的条件下可以检测细菌产硫化氢;溴麝香草酚兰和麝香草酚兰作为酸碱指示剂;琼脂起凝固的作用。在该平板上生长的细菌如果能利用蔗糖产酸, 则使得混合指示剂(溴麝香草酚兰和麝香草酚兰) 的颜色变成黄色。
(2)产品配制方法
称取本品8.9 g,煮沸溶解于100 mL蒸馏水中,冷至50℃时,倾入无菌平皿,备用。注:无需高压灭菌。
(3)弧菌接种至TCBS琼脂平板上,36℃±1℃需氧培养18 h-24 h,副溶血性弧菌为蓝绿色斗笠状菌落,H2S阴性;溶藻弧菌为黄色菌落,H2S阴性;霍乱弧菌为黄色菌落,H2S阴性。

图1 弧菌在TCBS琼脂平板上的菌落特征
2、庆大霉素琼脂
(1)检验原理
蛋白胨、牛肉浸粉提供氮源、维生素和生长因子;氯化钠维持均衡的渗透压;蔗糖提供碳源;亚硫酸钠可刺激弧菌生长;枸橼酸钠、庆大霉素和亚碲酸钾及较高的pH,可抑制革兰氏阳性菌和部分革兰氏阴性杂菌;霍乱弧菌对酸性环境比较敏感,因此该pH 值可增强其生长;琼脂是培养基的凝固剂。
添加剂:每瓶需配套添加1盒HB0123 1%亚碲酸钾溶液使用,每1000 mL庆大霉素琼脂添加0.5 mL HB0123。
(2)产品配制方法
称取本品149.5 g,加热溶解于1000 mL蒸馏水中,121℃高压灭菌15 min,备用。
(3)弧菌在庆大霉素琼脂平板上,36℃±1℃培养14 h-18 h,霍乱弧菌菌落扁平湿润,中心黑色,直径2 mm-3 mm;副溶血性弧菌菌落扁平湿润,中心黑色,直径小于1 mm。

图2 弧菌在庆大霉素琼脂平板上的菌落特征
3、氯化钠蔗糖琼脂
(1)检验原理
蛋白胨、牛肉浸粉提供氮源、维生素和生长因子;氯化钠维持均衡的渗透压,且较高浓度的氯化钠有利于弧菌的生长;蔗糖为可发酵糖类;溴麝香草酚蓝为酸碱指示剂;琼脂是培养基的凝固剂。
(2)产品配制方法
称取本品98 g,加热溶解于1000 mL蒸馏水中,121℃高压灭菌15 min,备用。
(3)弧菌在氯化钠蔗糖琼脂平板上,37℃需氧培养18 h-24 h,副溶血性弧菌为蓝绿色菌落,表面湿润;溶藻弧菌为黄色菌落。
a:副溶血性弧菌,b:溶藻弧菌
图3 弧菌在氯化钠蔗糖琼脂平板上的菌落特征
4、嗜盐菌选择性琼脂
(1)检验原理
蛋白胨为微生物的生长提供氮源和碳源;较高含量的氯化钠可抑制不耐高渗的细菌的生长;结晶紫抑制革兰氏阳性菌生长;琼脂是培养基的凝固剂;较高的pH可抑制部分杂菌的生长。
(2)产品配制方法
称取本品77.0 g,加热搅拌溶解于1000 mL蒸馏水中,分装,121℃高压灭菌15 min,备用。
(3)弧菌在嗜盐菌选择性琼脂平板上,36℃±1℃需氧培养18 h-24 h,副溶血性弧菌为无色菌落,较湿润;溶藻弧菌为无色菌落。

a:副溶血性弧菌ATCC 17802;b:溶藻弧菌ATCC 17749
图4 弧菌在嗜盐菌选择性琼脂平板上的菌落特征
5、氯化钠血琼脂基础
(1)检验原理
蛋白胨、酵母浸粉在培养基中作为营养物质提供菌体细胞生长所需的氮源、碳源等;甘露醇作为可发酵的碳源,发酵甘露醇产酸使得指示剂结晶紫变为黄色;高浓度的氯化钠作为选择因子可抑制非弧菌的生长;磷酸氢二钠作为缓冲体系;结晶紫作为酸碱指示剂;琼脂作为凝固剂。
添加剂:需配套添加无菌脱纤维兔血或人血使用。
(2)产品配制方法
称取本品11.3 g,煮沸溶解于100 mL蒸馏水中,待冷至45℃时,加入无菌脱纤维兔血或人血5 mL-10 mL,混合均匀,倾入无菌平皿,无需高压灭菌。
(3)弧菌在氯化钠血琼脂平板上,36℃±1℃需氧培养18 h-24 h,典型菌落特征为菌落周围有半透明β溶血环。
6、T1N1琼脂
(1)检验原理
胰蛋白胨提供生长必须的碳氮源;较高含量的氯化钠抑制不耐高渗透压的细菌;琼脂是培养基的凝固剂。
(2)产品配制方法
称取本品40.0 g,加热搅拌溶解于1000 mL蒸馏水中,121℃高压灭菌15 min,备用。
(3)弧菌在T1N1琼脂平板上,37℃±1℃需氧培养18 h-24 h,弧菌生长良好。

图5 弧菌在T1N1琼脂平板上的菌落特征
7、碱性琼脂
(1)检验原理
蛋白胨、牛肉浸粉提供碳氮源、维生素和生长因子;氯化钠维持均衡的渗透压;琼脂是培养基的凝固剂;较高的pH有利于抑制大肠菌群和其他杂菌的生长,有利于霍乱弧菌的生长。
(2)产品配制方法
称取本品33 g,加热搅拌溶解于1000 mL蒸馏水中,分装三角瓶,121℃高压灭菌15 min,备用。
(3)弧菌在碱性琼脂平板上36℃±1℃需氧培养18 h-24 h,副溶血性弧菌为无色透明菌落,霍乱弧菌为无色透明菌落,扁平湿润。

图6 弧菌在碱性琼脂平板上的菌落特征
8、碱性胆盐琼脂
(1)检验原理
蛋白胨、牛肉浸粉提供氮源、维生素和矿物质;氯化钠维持均衡的渗透压;牛胆盐抑制革兰氏阳性菌的生长;偏碱性的环境有利于弧菌的生长;琼脂是培养基的凝固剂。
(2)产品配制方法
称取本品47.0 g,加热搅拌溶解于1000 mL蒸馏水中,分装三角瓶,121℃高温灭菌15 min,备用。
(3)弧菌在碱性胆盐琼脂平板上,36℃±1℃需氧培养18 h-24 h,副溶血性弧菌为无色透明菌落,霍乱弧菌为无色透明菌落,扁平湿润。
图7 弧菌在甘碱性胆盐琼脂平板上的菌落特征
9、弧菌显色培养基(第二代)
(1)检验原理
弧菌显色培养基是青岛海博生物公司改良的培养基,用于食品、海产品、病人粪便样品和水产品中副溶血性弧菌的快速检测。副溶血性弧菌显蓝绿色且菌落比较大,霍乱弧菌和创伤弧菌显紫红色,溶藻弧菌显淡黄色或米黄色;其它细菌绝大部分被抑制。
本培养基的特异性高,可以克服TCBS培养基引起的假阴性结果,是一种很理想的快速检测培养基。利用弧菌自身代谢产生的酶与相应显色底物反应使菌落显色,以区分目标菌与非目标菌。显色底物是由产色因子和微生物部分可代谢物质组成,在特异性酶作用下,游离出产色因子使菌落显示一定颜色。
(2)产品配制方法
称取本品18.9 g,加入200 mL蒸馏水,加热溶解并不停搅拌,煮沸3-5次。冷却至45℃-50℃时,倾入无菌平皿。注意:制备好的培养基表面不能太干燥。
(3)弧菌在弧菌显色培养基(第二代)平板上,36℃±1℃需氧培养18 h-24 h,副溶血性弧菌显蓝绿色且菌落比较大,霍乱弧菌和创伤弧菌显紫红色,溶藻弧菌显淡黄色或米黄色。

图8 弧菌在弧菌显色培养基(第二代)平板上的菌落特征
10、MCPC培养基
(1)检验原理
蛋白胨、牛肉浸粉作为培养基中的基础营养物质,提供细菌生长所需的碳氮源、维生素和其他的生长因子;氯化钠维持培养基体系的渗透压平衡;多粘菌素B和多粘菌素E能抑制副溶血性弧菌和溶藻弧菌等非目标菌的生长;纤维二糖为可发酵的糖类;溴百里酚兰和甲酚红为pH指示剂;琼脂是培养基的凝固剂。
添加剂:每瓶需配套添加10盒HB4151a CPC培养基添加剂和10盒HB4151b 10%纤维二糖水溶液使用。
(2)产品配制方法
称取本品50.0 g,加热煮沸溶解900 mL蒸馏水中,分装每瓶90 mL,冷却到48℃-55℃时,加入10%纤维二糖溶液10 mL和1支mCPC添加剂(多粘菌素E 40000 units和多粘菌素B 10000 units)混匀,倾入平皿,无需高压灭菌。
(3)弧菌在MCPC培养基平板上,36℃±1℃需氧培养18 h-24 h,副溶血性弧菌为圆形扁平,中心不透明,边缘透明的黄色菌落,霍乱弧菌为紫色菌落。

图9 弧菌在MCPC培养基平板上的菌落特征
11、副溶血性弧菌琼脂
(1)检验原理
蛋白胨、酵母浸粉提供碳氮源、维生素和生长因子;氯化钠可刺激弧菌的生长;蔗糖是可发酵的糖类;牛胆盐、硫代硫酸钠、柠檬酸钠及较高的pH可抑制革兰氏阳性菌和大肠菌群;霍乱弧菌对酸性环境比较敏感,因此该pH值可增强其生长;溴麝香草酚兰和麝香草酚兰是pH指示剂;琼脂是培养基的凝固剂。
(2)产品配制方法
称取本品100.28 g,加热煮沸溶解于1000 mL蒸馏水中,冷至45℃-50℃左右时,倾入无菌平皿。
(3)弧菌在副溶血性弧菌琼脂平板上,36℃±1℃需氧培养18 h-24 h,溶藻弧菌、霍乱弧菌和河流弧菌为黄色菌落,创伤弧菌和副溶血性弧菌为绿色菌落。
图10 弧菌在副溶血性弧菌琼脂平板上的菌落特征
12、四号琼脂
(1)检验原理
蛋白胨、牛肉粉提供碳氮源、维生素和生长因子;氯化钠维持均衡的渗透压;亚硫酸钠可刺激弧菌生长;柠檬酸钠、十二烷基硫酸钠、牛胆粉、利凡诺、庆大霉素和亚碲酸钾及较高的pH可抑制革兰氏阳性菌和部分革兰氏阴性杂菌;霍乱弧菌对酸性环境比较敏感,因此该pH值可增强其生长;琼脂是培养基的凝固剂。
添加剂:每瓶需配套添加1盒HB0123 1%亚碲酸钾溶液使用。
(2)产品配制方法
称取本品60.0 g,加热溶解于1000 mL蒸馏水中,冷至50℃-55℃时,每1000 mL培养基中加入无菌1%亚碲酸钾溶液1 mL,混匀,倾入无菌平皿,备用。注:无需高压灭菌。
(3)弧菌在四号琼脂平板上,36℃±1℃需氧培养14 h-18 h,霍乱弧菌为菌落扁平湿润,中心黑色,直径2 mm-3 mm,副溶血性弧菌菌落小于1 mm。

图11 弧菌在四号琼脂平板上的菌落特征
13、纤维二糖-多粘菌素E(CC)琼脂
(1)检验原理
蛋白胨、牛肉粉提供氮源、维生素和生长因子;氯化钠维持均衡的渗透压;纤维二糖为可发酵的糖类;多粘菌素B和多粘菌素E能抑制副溶血性弧菌和溶藻弧菌等非目标菌的生长;溴麝香草酚蓝和甲酚红为pH指示剂;琼脂是培养基的凝固剂。
添加剂:每瓶需配套添加10盒HB4151-1a CC琼脂添加剂和10盒HB4151b 10%纤维二糖水溶液使用,每90 mL CC琼脂添加1支HB4151-1a和2支HB4151b。
(2)产品配制方法
称取本品50.0 g,加热煮沸溶解于900 mL蒸馏水中,分装每瓶90 mL,冷却到48℃-55℃时,加入10%纤维二糖溶液10 mL和1支CC琼脂添加剂(多粘菌素E 40000 units)混匀,倾入无菌平皿,无需高压灭菌。
(3)弧菌在纤维二糖-多粘菌素E(CC)琼脂平板上,36℃±1℃需氧培养18 h-24 h,创伤弧菌为圆形扁平,中心不透明,边缘透明的黄色菌落,霍乱弧菌为紫色菌落,副溶血性弧菌被抑制。

1.创伤弧菌ATCC27562 2.副溶血性弧菌ATCC17802 3.霍乱弧菌非01群
图12 弧菌在纤维二糖-多粘菌素E(CC)琼脂平板上的菌落特征
14、CPC琼脂基础
(1)检验原理
蛋白胨、䏡胨提供细菌生长的基本营养,稍高含量的氯化钠、氯化镁和氯化钾提供与海水相近的渗透压,有利于弧菌的生长,溴麝香草酚蓝和甲酚红为酸碱指示剂,酸性条件下均显黄色,溴麝香草酚蓝碱性条件下显蓝色,甲酚红碱性条件下显紫红色,纤维二糖为可发酵碳源,较高浓度的多粘菌素B和多粘菌素E可抑制大多数革兰氏阴性菌的生长。创伤弧菌可在此培养基中生长,分解纤维二糖产酸,菌落呈黄色,菌落周围因产酸也变为黄色。其他不能利用纤维二糖的弧菌,菌落通常呈蓝绿色至紫红色。
添加剂:需配套HB4151b 10%纤维二糖水溶液和HB8852a CPC琼脂添加剂。
(2)产品配制方法
称取本品45.95 g,加热煮沸溶解于900 mL蒸馏水中,分装,每瓶90 mL,冷却至48℃-55℃左右时,每90 mL培养基中加入无菌10%纤维二糖溶液15 mL和1支CPC琼脂添加剂(多粘菌素B 40000IU、多粘菌素E 100000IU),混匀,倾入无菌平皿,备用。
(3)弧菌在CPC琼脂平板上,36℃±1℃需氧培养18 h-24 h,创伤弧菌为黄色菌落,周围变黄,霍乱弧菌为蓝绿色至紫色菌落,周围变紫。

图13 弧菌在CPC琼脂平板上的菌落特征
三、产品展示
我公司有多种弧菌检测的培养基,客户可根据实际应用情况和用途进行选用。
表1 部分产品信息
|
产品货号 |
产品名称 |
规格 |
用途 |
|
HB4130 |
250g/瓶 |
用于致病性弧菌的选择性分离 |
|
|
HB4133-2 |
250g/瓶 |
用于霍乱弧菌的分离培养(GB标准) |
|
|
HB4142 |
250g/瓶 |
用于副溶血性弧菌的选择性分离培养 |
|
|
HB4143 |
250g/瓶 |
用于副溶血性弧菌的选择性分离培养(GB标准) |
|
|
HB4144 |
250g/瓶 |
用于副溶血性弧菌的溶血试验(GB标准) |
|
|
HB4146 |
250g/瓶 |
用于霍乱弧菌的培养(SN标准) |
|
|
HB8402 |
250g/瓶 |
用于霍乱弧菌的分离培养 |
|
|
HB8403 |
250g/瓶 |
用于霍乱弧菌分离培养 |
|
|
HB7011-5 |
1000mL/瓶 |
用于弧菌的显色培养,副溶血性弧菌显蓝绿色,霍乱弧菌和创伤弧菌显紫红色,溶藻弧菌显淡黄色或米黄色 |
|
|
HB4151 |
250g/瓶 |
用于致病性弧菌的选择性分离 |
|
|
HB4184 |
250g/瓶 |
用于副溶血性弧菌的选择性分离培养 |
|
|
HB4134 |
250g/瓶 |
用于霍乱弧菌的选择性分离培养 |
|
|
HB4151-2 |
250g/瓶 |
用于创伤弧菌分离培养基 |
|
|
HB8852 |
250g/瓶 |
用于创伤弧菌的分离培养 |
注:本文属海博生物原创,未经允许不得转载。
上一篇:LB培养基的介绍与应用
下一篇:微生物在生态系统中的主要作用
| 相关文章: | ||



